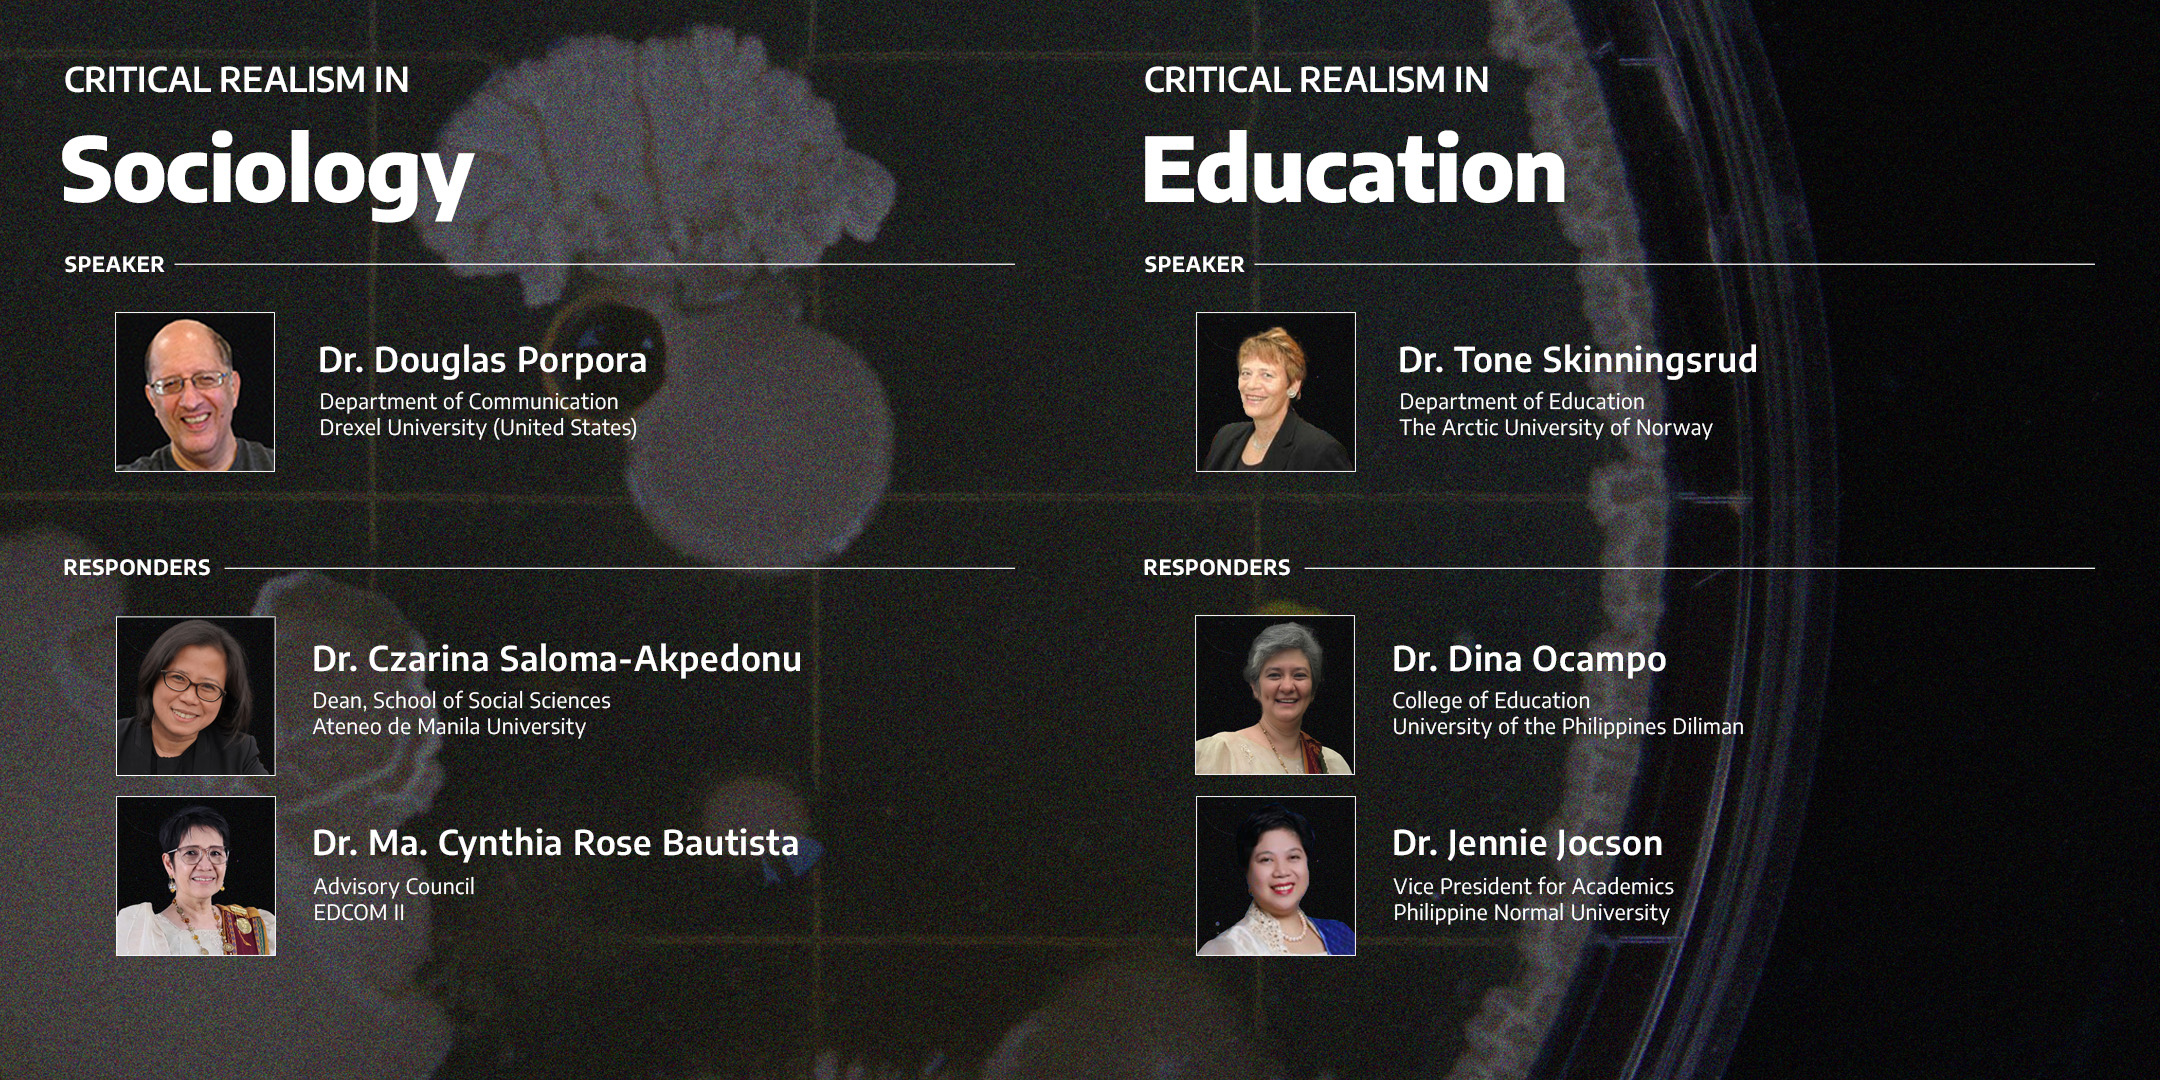
IACR Across The Disciplines Panel Discussion
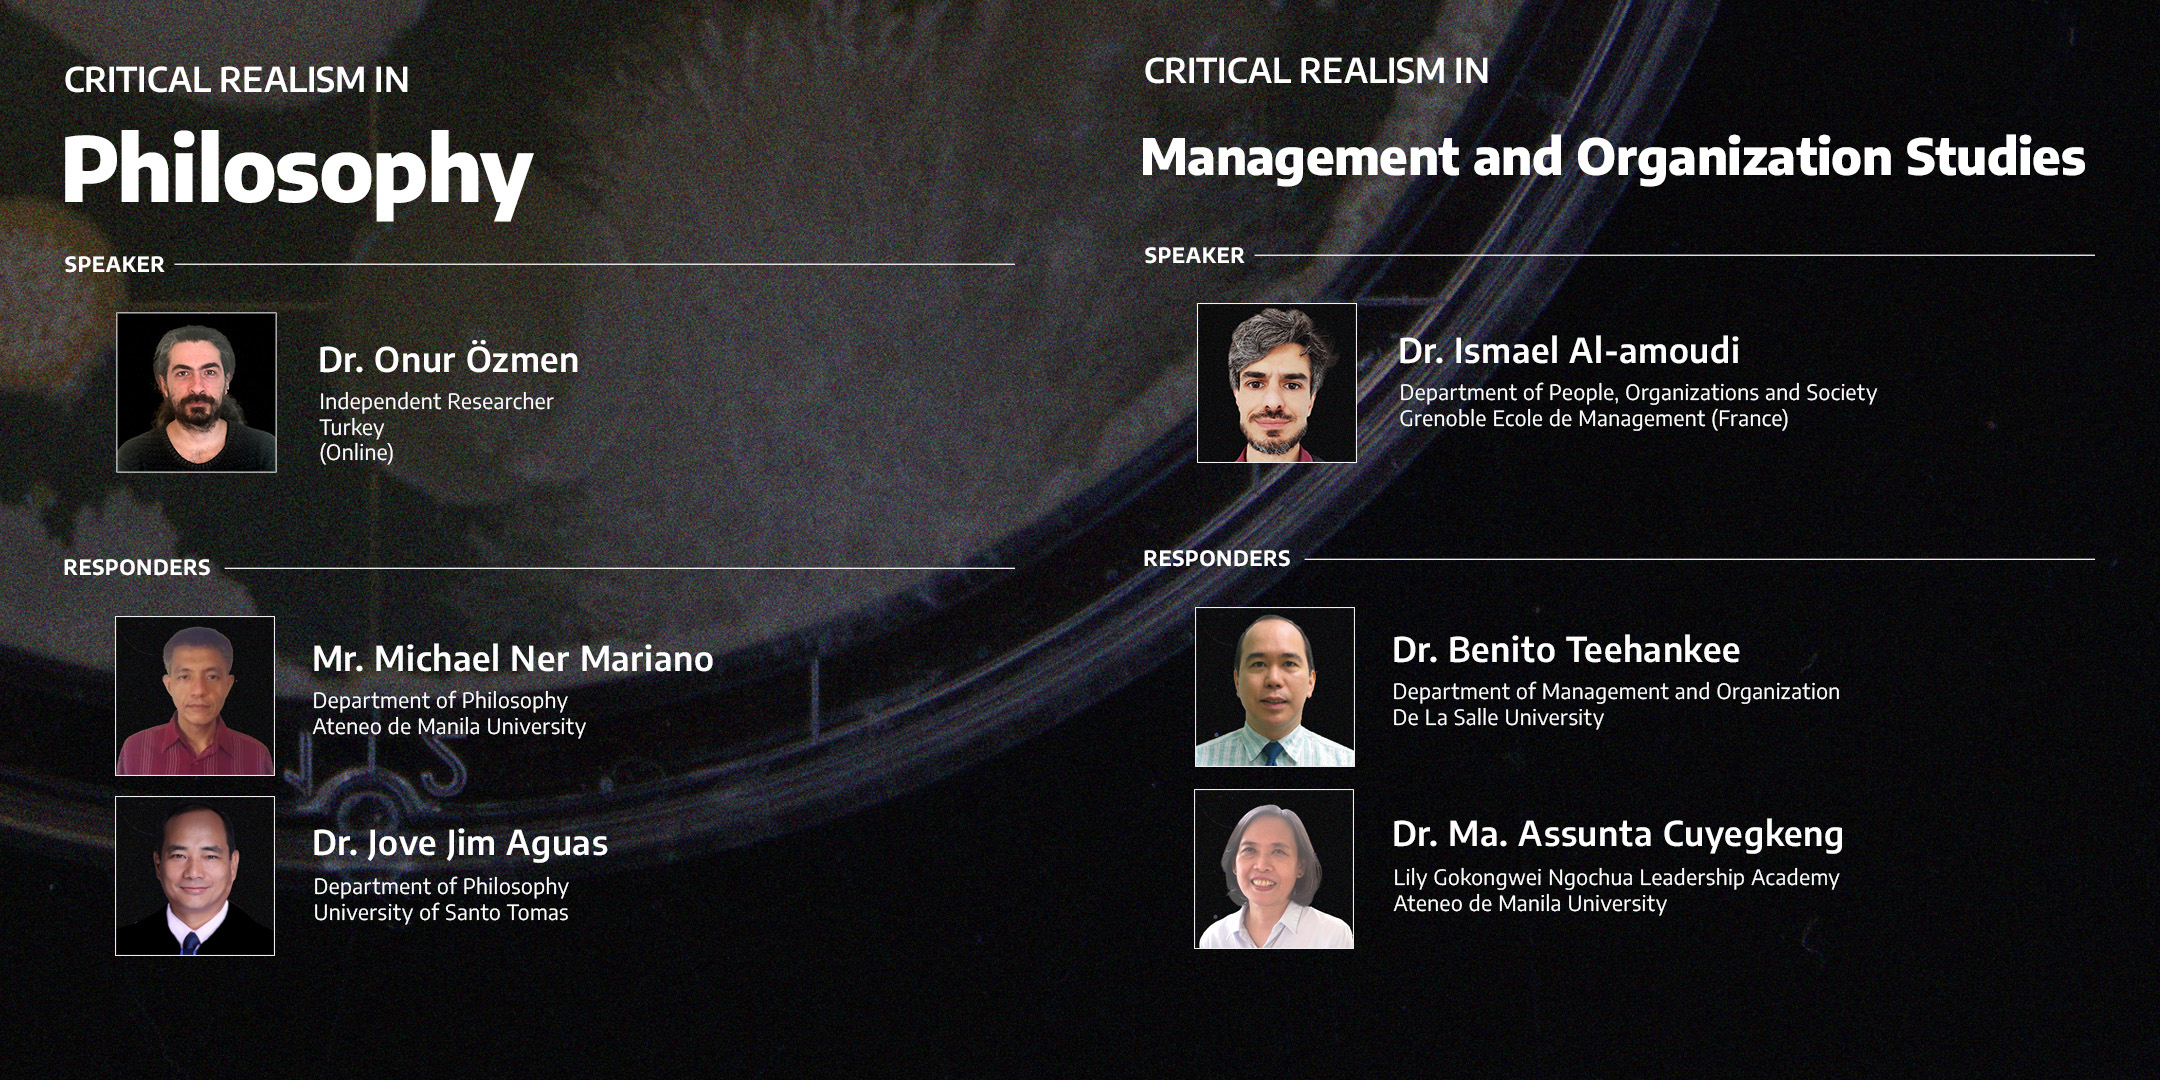
IACR Across The Disciplines Panel Discussion
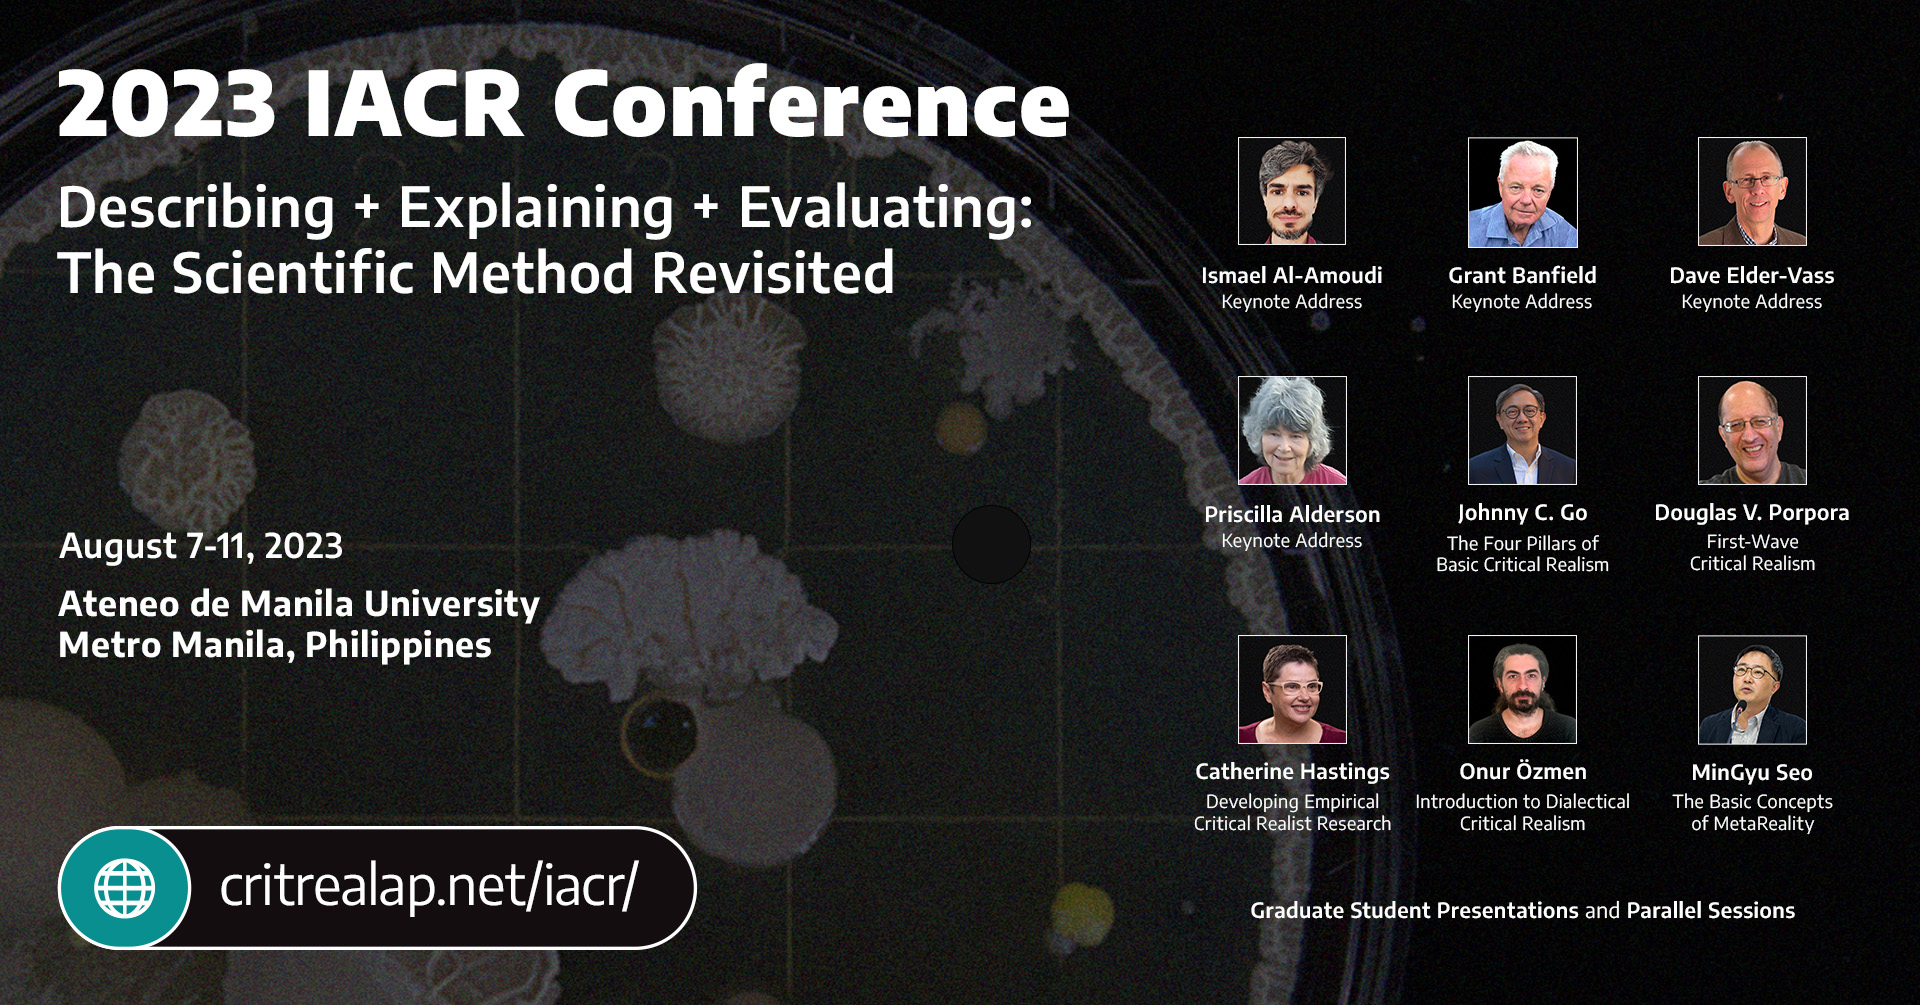
2023 IACR Conference

2023 IACR Conference
This year’s International Conference on Critical Realism will be hosted by the Ateneo de Manila University in the Philippines. It will be both an in-person and online event, but we hope you will consider attending the conference onsite!
Our conference theme is “DESCRIBING + EXPLAINING + EVALUATING: THE SCIENTIFIC METHOD REVISITED”–a theme that intends to provide scholars and researchers–both critical realist and not–an opportunity to take a step back and reflect on the way we investigate phenomena and the underlying assumptions that shape the way we describe and explain them.
In the morning of Day 2 of the Conference (10 August 2023), there will be four panel discussions featuring critical realist scholars who will share how critical realism has informed and enriched their work, followed by a dialogue with other researchers.

For more information visit critrealap.net/iacr.